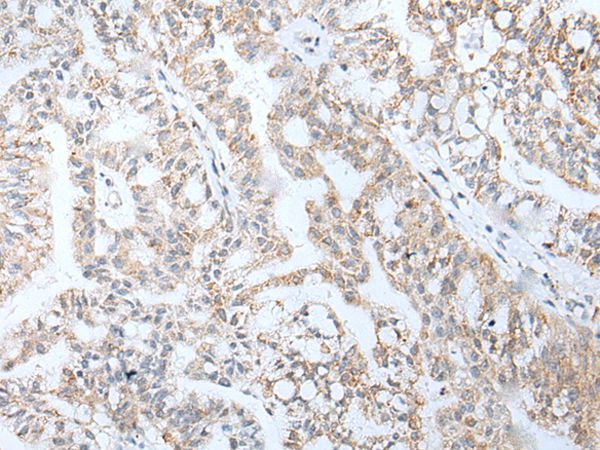

Goat anti-Homeobox A5
EB08093
ApplicationsELISA
Product group Antibodies
TargetHOXA5
Overview
- SupplierEverest Biotech
- Product NameGoat anti-Homeobox A5 Antibody
- Delivery Days Customer5
- ApplicationsELISA
- Applications SupplierPep-ELISA
- CertificationResearch Use Only
- ClonalityPolyclonal
- Concentration0.5 mg/ml
- Gene ID3202
- Target nameHOXA5
- Target descriptionhomeobox A5
- Target synonymshomeo box 1C; homeo box A5; homeobox protein Hox-1C; homeobox protein HOXA5; homeobox protein Hox-A5; HOX1; HOX1.3; HOX1C
- HostGoat
- Scientific DescriptionRefSeq number(s): NP_061975.2. GeneIDs all Nonhuman: 15402 (mouse);. Purification: Antigen affinity purified. Names and symbols: HOXA5; homeobox A5; HOX1; HOX1.3; HOX1C; MGC9376; homeo box 1C; homeo box A5; homeobox protein HOXA5
- Reactivity SupplierHuman, Mouse
- Storage Instruction-20°C
- UNSPSC12352203